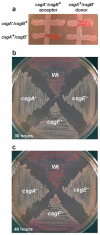

Curli biogenesis and function
- PMID: 16704339
- PMCID: PMC2838481
- DOI: 10.1146/annurev.micro.60.080805.142106
Curli biogenesis and function
Abstract
Curli are the major proteinaceous component of a complex extracellular matrix produced by many Enterobacteriaceae. Curli were first discovered in the late 1980s on Escherichia coli strains that caused bovine mastitis, and have since been implicated in many physiological and pathogenic processes of E. coli and Salmonella spp. Curli fibers are involved in adhesion to surfaces, cell aggregation, and biofilm formation. Curli also mediate host cell adhesion and invasion, and they are potent inducers of the host inflammatory response. The structure and biogenesis of curli are unique among bacterial fibers that have been described to date. Structurally and biochemically, curli belong to a growing class of fibers known as amyloids. Amyloid fiber formation is responsible for several human diseases including Alzheimer's, Huntington's, and prion diseases, although the process of in vivo amyloid formation is not well understood. Curli provide a unique system to study macromolecular assembly in bacteria and in vivo amyloid fiber formation. Here, we review curli biogenesis, regulation, role in biofilm formation, and role in pathogenesis.
Figures

References
-
- Arnqvist A, Olsen A, Normark S. Sigma S-dependent growth-phase induction of the csgBA promoter in Escherichia coli can be achieved in vivo by sigma 70 in the absence of the nucleoid-associated protein H-NS. Mol. Microbiol. 1994;13:1021–32. - PubMed
-
- Arnqvist A, Olsen A, Pfeifer J, Russell DG, Normark S. The Crl protein activates cryptic genes for curli formation and fibronectin binding in Escherichia coli HB101. Mol. Microbiol. 1992;6:2443–52. - PubMed
-
- Austin JW, Sanders G, Kay W, Collinson S. Thin aggregative fimbriae enhance Salmonella enteritidis biofilm formation. FEMS Microbiol. Lett. 1998;162:295–301. - PubMed
-
- Ben Nasr A, Olsen A, Sjobring U, Muller-Esterl W, Bjorck L. Assembly of human contact phase proteins and release of bradykinin at the surface of curli-expressing Escherichia coli. Mol. Microbiol. 1996;20:927–35. - PubMed
Publication types
MeSH terms
Substances
Grants and funding
LinkOut - more resources
Full Text Sources
Other Literature Sources
Molecular Biology Databases
Miscellaneous